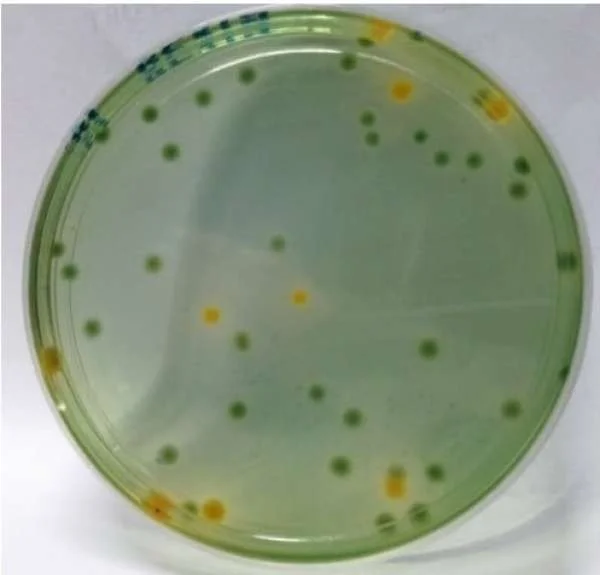
Chống Vibrio Trong Nuôi Tôm: Chiến Lược Hiệu Quả Đối Phó Với Bệnh Tật

Chống Khí Độc Ao Tôm: Chiến Lược Bảo Vệ Sức Khỏe và Môi Trường
Khí độc trong ao tôm là một vấn đề nghiêm trọng có thể gây ra các vấn đề sức khỏe cho tôm và nguy cơ cho môi trường nuôi tôm. Trong bối cảnh ngành chăn nuôi tôm đang phát triển mạnh mẽ, việc xử lý khí độc trở thành một ưu tiên hàng đầu. Dưới đây là một phân tích chi tiết về nguy cơ của khí độc ao tôm và các hướng xử lý phổ biến.
Nguy cơ của khí độc ao tôm
- Giảm lượng oxy hòa tan: Trong quá trình nuôi tôm, sự suy giảm lượng oxy hòa tan trong nước có thể dẫn đến tình trạng thiếu oxy, gây stress và tử vong cho tôm.
- Tăng nồng độ NH3 và H2S: Việc phân hủy chất thải hữu cơ trong ao tôm tạo ra khí NH3 (ammonia) và H2S (hydrogen sulfide), hai chất độc hại đối với tôm.
- Ảnh hưởng đến sức khỏe tôm: Khí độc, đặc biệt là NH3 và H2S, có thể gây ra các vấn đề về hô hấp, tiêu hóa và gây stress cho tôm, ảnh hưởng đến sức khỏe và tăng tỷ lệ tử vong.
- Nguy cơ cho môi trường: Việc thải những loại khí độc này ra môi trường nước không chỉ gây tổn thương cho tôm mà còn ảnh hưởng đến hệ sinh thái nước, gây ra ô nhiễm môi trường.
Hướng xử lý khí độc ao tôm
- Kiểm soát lượng thức ăn và chất thải: Giảm lượng thức ăn cho tôm và kiểm soát việc thải chất thải hữu cơ từ ao tôm để hạn chế quá trình phân hủy và sản sinh ra NH3 và H2S.
- Tăng cường tuần hoàn nước: Cải thiện hệ thống tuần hoàn nước trong ao tôm để cung cấp đủ oxy và loại bỏ các chất độc hại, giúp duy trì môi trường nước lý tưởng cho sự phát triển của tôm.
- Sử dụng hệ thống lọc nước: Lắp đặt các hệ thống lọc nước hiệu quả để loại bỏ chất hữu cơ và chất độc hại khác từ ao tôm, giảm nguy cơ của khí độc.
- Thực hiện quản lý định kỳ: Đảm bảo thực hiện các biện pháp quản lý định kỳ như kiểm tra chất lượng nước, giám sát môi trường ao, và thử nghiệm khí độc để phát hiện sớm và xử lý vấn đề.
- Sử dụng phụ gia xử lý nước: Sử dụng các phụ gia xử lý nước như vi khuẩn xử lý, enzym và hóa chất khử độc để giảm lượng NH3 và H2S trong ao tôm.
- Áp dụng kỹ thuật nuôi tôm sạch: Sử dụng các kỹ thuật nuôi tôm sạch như nuôi tôm theo mô hình hợp lý, sử dụng hệ thống nuôi cấy cây thủy sinh để hấp thụ chất thải và cải thiện chất lượng nước.
Triển vọng và những hướng đi tiếp theo
Việc xử lý khí độc trong ao tôm không chỉ giúp cải thiện sức khỏe của tôm mà còn giữ gìn môi trường nước. Sự kết hợp giữa công nghệ và quản lý chăn nuôi sẽ tiếp tục là chìa khóa để giảm thiểu nguy cơ của khí độc và thúc đẩy phát triển bền vững của ngành công nghiệp thủy sản.